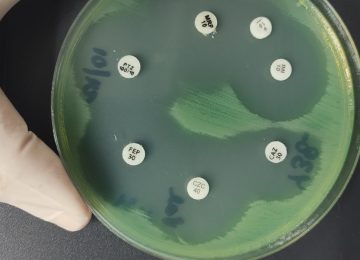
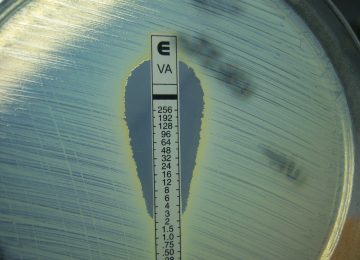

¿Qué aprenderás en este curso?
Competencia general de aprendizaje:
Integrar y aplicar críticamente el conocimiento de los mecanismos de acción de los antimicrobianos para optimizar su escogencia en el tratamiento de infecciones bacterianas y fúngicas.
Competencias específicas:
1) Categorizar las dianas de los agentes antimicrobianos en bacterias y hongos, con el fin de predecir el impacto de cada fármaco sobre la viabilidad microbiana.
2) Correlacionar la estructura básica de bacterias Gram positivas, Gram negativas, levaduras y mohos con los blancos de acción específicos de los antimicrobianos, para fundamentar las diferencias en la actividad y el espectro de estos fármacos.
3) Clasificar y organizar los agentes antimicrobianos basados en la comprensión profunda de sus mecanismos de acción, para optimizar la elección terapéutica y favorecer el uso racional de los antimicrobianos en la práctica clínica.
4) Evaluar los nuevos agentes antimicrobianos incorporados al arsenal terapéutico, determinando su utilidad y rol específico en el manejo de patógenos con perfiles de resistencias complejos.
Duración: 8 semanas.
Carga horaria: 30 horas de estudio.
Aula: guiasdemicro.com
- Atención personalizada
- Casos de estudio
- Actividades interactivas
- Bibliografía científica
- Foros de discusión
- Flexibilidad de aprendizaje
- Aula disponible 24/7
- Experiencias significativas
Facilitadoras
Antimicrobianos en infecciones bacterianas por la Lcda. Carolina Macero.
Antimicrobianos en infecciones fúngicas por la Dra. Xiomara Moreno.
MÓDULO 1.
Introducción al programa académico y funcionamiento del aula.
Antimicrobianos en infecciones bacterianas.
Unidad 1. Breve reseña histórica.
Unidad 2. Definiciones y conceptos generales.
Actividades propuestas en aula:
Foro de presentación.
Foro de discusión.
Materiales: 4 videos, 3 lecturas y ejercicios de autoevaluación.
Tiempo sugerido: 4 horas para completar.
MÓDULO 2.
Antimicrobianos en infecciones bacterianas.
Unidad 3. Clasificación según su mecanismo de acción.
Unidad 4. Inhibidores de la síntesis de la pared celular.
Unidad 5. Modificadores de la membrana citoplasmática.
Actividades propuestas en aula:
Foro de discusión.
Materiales: 6 videos, 2 lecturas y ejercicios de autoevaluación.
Tiempo sugerido: 5 horas para completar
MÓDULO 3.
Antimicrobianos en infecciones bacterianas.
Unidad 6. Inhibidores de la síntesis de proteínas bacterianas.
Unidad 7. Inhibidores de la síntesis de ácidos nucleicos.
Actividades propuestas en aula:
Foro de discusión.
Materiales: 4 videos, 2 lecturas y ejercicios de autoevaluación.
Tiempo sugerido: 4 horas para completar
MÓDULO 4.
Antimicrobianos en infecciones bacterianas.
Unidad 8. Inhibidores de la síntesis de factores metabólicos
Unidad 9. Inhibidores de enzimas betalactamasas.
Unidad 10. Nuevas drogas, nuevos mecanismos de acción.
Actividades propuestas en aula:
Foro de discusión.
Materiales: 4 videos, 3 lecturas y ejercicios de autoevaluación.
Tiempo sugerido: 4 horas para completar
MÓDULO 5.
Antimicrobianos en infecciones fúngicas.
Unidad 1. Características de la célula fúngica.
Unidad 2. Reseña histórica y generalidades de los antifúngicos.
Unidad 3. Polienos (Desestabilizadores de la membrana celular)
Unidad 4. Azoles (inhibidores de la síntesis del ergosterol) – Parte I
Unidad 5. Alilaminas y Bencilaminas (Inhibidores de la síntesis del ergosterol) – Parte II
Actividades propuestas en aula:
Foro de discusión.
Materiales: 5 videos, 5 lecturas y ejercicios de autoevaluación.
Tiempo sugerido: 4 horas para completar
MÓDULO 6.
Antimicrobianos en infecciones fúngicas.
Unidad 6. Candinas (Inhibidores de la síntesis de la pared celular)
Unidad 7. Inhibición de los ácidos nucleicos- proteínas, mitosis-microtúbulos
Unidad 8. Nuevas drogas antifúngicas en estudio – Parte I
Unidad 9. Nuevas drogas antifúngicas en estudio – Parte II
Actividades propuestas en aula:
Foro de discusión.
Materiales: 5 videos, 2 lecturas y ejercicios de autoevaluación.
Tiempo sugerido: 4 horas para completar
MÓDULO 7.
Ejercicios de consolidación.
Repaso
Actividades propuestas en aula:
Ejercicios de repaso
Dos foros de repaso: antimicrobianos en infecciones bacterianas y antimicrobianos en infecciones fúngicas.
Tiempo sugerido: 4 horas para completar.
MÓDULO 8.
Prueba final
Actividades propuestas en el aula:
Evaluación final, foro de finalización y encuesta.
Entrega de certificados.
El desarrollo e historia de la humanidad ha sido moldeada e impactada por la aparición de innumerables enfermedades infecciosas; hoy día vemos como nuevamente la aparición de una pandemia exige un reto inmenso y moldea el futuro de los seres humanos; el desarrollo de medidas de control y saneamiento ambiental, vacunas, el conocimiento de la ecología y cadenas de contagio de las enfermedades infecciosas, además del desarrollo de antimicrobianos, ha permitido el crecimiento, mejora en la expectativa y calidad de vida de los humanos. Es inconcebible no ligar el desarrollo actual de la medicina, a la prevención, control y tratamiento de las infecciones, es imposible realizar cirugías, tratamientos intensivos del cáncer o trasplante de órganos, sin tener a la disposición medidas de prevención y tratamiento de las posibles complicaciones infecciosas que puedan aparecer en los individuos sometidos a estos tratamientos.
La historia de la farmacología y tratamiento antimicrobiano moderno, inicia a principios del Siglo XX cuando el Dr. Paul Ehrlich (Premio Nobel de Medicina año 1908) desarrolla en el año 1906 su teoría de las “Balas Mágicas” dividiendo la terapéutica en tres categorías: Organoterapia (Hormonas), Bacterioterapia (agentes inmunológicos) y Quimioterapia experimental (drogas que actuarán y se fijarán sobre los microorganismos pero que no se unirán a las células normales y las dañarán) desarrollando las primeras moléculas antimicrobianas: el “Salvarsán 606″ y el “Neosalvarsán 914”.
En el año 1928, el Dr. Alexander Fleming en otro hito de la historia de la humanidad, descubre la penicilina, pero no sería hasta los años 1939 a 1941, cuando los Dres. Ernest B. Chain y Howard W. Florey, desarrollan un método industrial para la elaboración en masa del producto (los tres fueron acreedores del Premio Nobel de Medicina en el año 1945). Durante esos años se producía uno de los acontecimientos más penosos del siglo XX, “La Segunda Guerra Mundial”. El descubrimiento y posterior desarrollo y producción en masa de la penicilina fue determinante en los acontecimientos acaecidos durante la guerra, porque puso a disposición de los ejércitos aliados un medicamento que les permitía tratar múltiples enfermedades en los soldados, evitaba cirugías que producían incapacidades permanentes y a fin de cuentas permitía reincorporar a los soldados al frente de batalla en menor tiempo, lo que les dio una ventaja adicional y fue de vital importancia para la victoria de los ejércitos de los aliados sobre los del eje del mal.
 Hoy día nuevamente nos enfrentamos a uno de los problemas más importantes que afectan a los seres humanos, como es la resistencia a las drogas antimicrobianas, y está categorizado como uno de las grandes situaciones que nos afectan. Los estudiosos del tema estiman, que si hoy no hacemos algo para poner freno a la resistencia antimicrobiana, para el año 2050 podrían morir alrededor de 10 millones de personas a consecuencia de la misma, por eso, junto con el cambio climático y la distribución anómala y crecimiento desproporcionado de la población, es uno de los grandes retos del futuro.
Hoy día nuevamente nos enfrentamos a uno de los problemas más importantes que afectan a los seres humanos, como es la resistencia a las drogas antimicrobianas, y está categorizado como uno de las grandes situaciones que nos afectan. Los estudiosos del tema estiman, que si hoy no hacemos algo para poner freno a la resistencia antimicrobiana, para el año 2050 podrían morir alrededor de 10 millones de personas a consecuencia de la misma, por eso, junto con el cambio climático y la distribución anómala y crecimiento desproporcionado de la población, es uno de los grandes retos del futuro.
Por todo lo anterior, es propicio presentar a ustedes el curso virtual “Principios básicos de los antimicrobianos”, dictado en la plataforma de Guías de Micro por la Lcda. Carolina Macero y la Dra. Xiomara Moreno, quienes han desarrollado una aquilatada experiencia en el mundo de la microbiología.
Hemos trabajado y compartido experiencias juntos en los últimos 20 años entre la Unidad de Infectología y el Laboratorio de Microbiología del Instituto Médico La Floresta y estoy completamente seguro que aquellos que decidan navegar durante estas semanas el fascinante mundo de los antimicrobianos de la guía de estas dos excelentes profesionales, al finalizar el curso, obtendrán los conocimientos para tener una visión diferente en el uso de este excelente arsenal terapéutico, y serán ustedes claves en contribuir con el uso adecuado y racional de los antimicrobianos, y con su pequeño granito de arena podrían modificar la historia futura de la humanidad.
Dr. Rafael Napoleón Guevara.
Médico Internista – Infectólogo
Expresidente de la Sociedad Venezolna de Infectología
Miembro titular de la Sociedad Venezolana de Microbiologia
“La resistencia a los antimicrobianos es hoy una de las mayores amenazas para la salud mundial. Cada vez es mayor el número de infecciones cuyo tratamiento se vuelve más difícil debido a la pérdida de eficacia de los antimicrobianos, lo que trae como consecuencia una prolongada estancia hospitalaria, incremento de costos médicos y aumento de la mortalidad. La lucha contra la resistencia a los antibióticos reviste en la actualidad alta prioridad para la OMS, es por ello que la Asamblea Mundial de la Salud aprobó, en mayo de 2015, un plan de acción mundial sobre la resistencia a los antimicrobianos. Su finalidad era asegurar que se pueda seguir previniendo y tratando enfermedades infecciosas por medio de fármacos eficaces y seguros. Este plan contiene cinco objetivos estratégicos entre los cuales el principal establece mejorar la sensibilización y los conocimientos en materia de resistencia a los antimicrobianos, siendo la educación el eje fundamental para el logro de dicho objetivo, es por ello que resulta de gran importancia comprender los blancos de acción de los distintos agentes antimicrobianos, así como entender su mecanismo de acción frente a bacterias y hongos, esto permitirá optimizar el uso de los mismos disminuyendo así la posibilidad de resistencia antimicrobiana. En base a lo anterior se concluye que este curso, sobre los “Principios Básicos de los Antimicrobianos”, contribuirá a lograr los objetivos estratégicos planteados por la OMS”.

Dra. Tatiana Drummond
Infectóloga-Pediatra
Coordinadora del postgrado de Infectología Pediátrica del Hospital Universitario de Caracas-Venezuela.
IG@dratatianadrummond
“La mejor manera de combatir a las bacterias, hongos y demás microorganismos patógenos es conocer dos cosas: las variables inherentes a los microorganismos, como las diferentes fases del crecimiento y sus componentes estructurales, y las inherentes a los antimicrobianos, como la biodisponibilidad, eliminación y distribución en los distintos órganos y sistemas y el efecto final ejercido como bactericidas o bacteriostáticos. Los primeros serán más efectivos en infecciones severas o en pacientes inmunocomprometidos, que los segundos. Así mismo, según su modo de acción, contamos con los antimicrobianos tiempo dependiente y concentración dependiente. El conocimiento de estas variables aunado a los mecanismos de resistencia intrínsecos como adquiridos, son fundamentales para la optimización del tratamiento antimicrobiano”.

Dra. María Eugenia Guzmán Siritt.
Médico Adjunto del Servicio de Infectología del Hospital Militar “Carlos Arvelo”.
Profesor del postgrado de Infectología del Hospital Militar “Carlos Arvelo”.
Médico Internista-Infectólogo en el Instituto Médico La Floresta.
Miembro de la Sociedad Venezolana de Infectología.
“El conocimiento de los mecanismos de acción de los antimicrobianos es muy importante para el tratamiento de las infecciones causadas por bacterias y hongos, ya que la inhibición de su crecimiento o su muerte depende directamente del blanco de acción donde actúan. Este curso cuenta con docentes de excelente preparación para lograr el objetivo propuesto”.

MSc. María Mercedes Panizo.
Lcda. en Bioanálisis.
MSc. en Micología y en Sistemas de Calidad.
Consultores Sigma APS.
Presidenta de la Sociedad Venezolana de Microbiología.
IG: @mechepanizo
Linkedin: Mercedes Panizo
“La evolución de la Microbiología Clínica es sencillamente fascinante. Hace unos años se evaluaba la susceptibilidad a los antimicrobianos simplemente a través de puntos de corte que permitían categorizar sensibilidad o resistencia, y eso era suficiente, pero los microorganismos con sus mecanismos de resistencia se han encargado de transformar esta área, y hoy en día el foco es detectar dicho(s) mecanismo(s) permitiendo activar una serie de protocolos para generar alertas a microbiólogos, clínicos y epidemiólogos. Es imprescindible, para la comprensión de la resistencia a los antimicrobianos, partir del conocimiento en detalle de estas moléculas, su estructura química que permite clasificarlas en familias, el modo de acción bactericida y/o bacteriostático, las características farmacocinéticas y farmacodinámicas, sobre cuál estructura microbiana actúan, y así poder realizar la elección correcta para el cuadro infeccioso del paciente.
Los invito a participar en este curso, por medio de la plataforma de Guías de Micro, para todo aquel interesado en profundizar este importante aspecto de la Microbiología, recordando que el recurso humano altamente capacitado es el más importante en la lucha contra la resistencia a los antimicrobianos”.

Esp. Luis Carlos Torres C.
Representante Especialista en Antiinfectivos Pfizer Chile.
Lcdo. en Bioanálisis
Microbiólogo Clínico
Expresidente de la Sociedad Venezolana de Microbiología.
IG: @ltorresucv
“No se pueden comprender los mecanismos de resistencia de las bacterias y los hongos si antes no se profundiza en el conocimiento del mecanismo de acción de los antimicrobianos. Este curso proporciona las herramientas necesarias para su aprendizaje utilizando las nuevas tecnologías digitales”.

Dra. Vera Reviakina.
Médico Microbiólogo.
MSc. en Micología.
Comisión editora de la Revista de la Sociedad Venezolana de Microbiología.
Linkedin: Vera Reviakina

